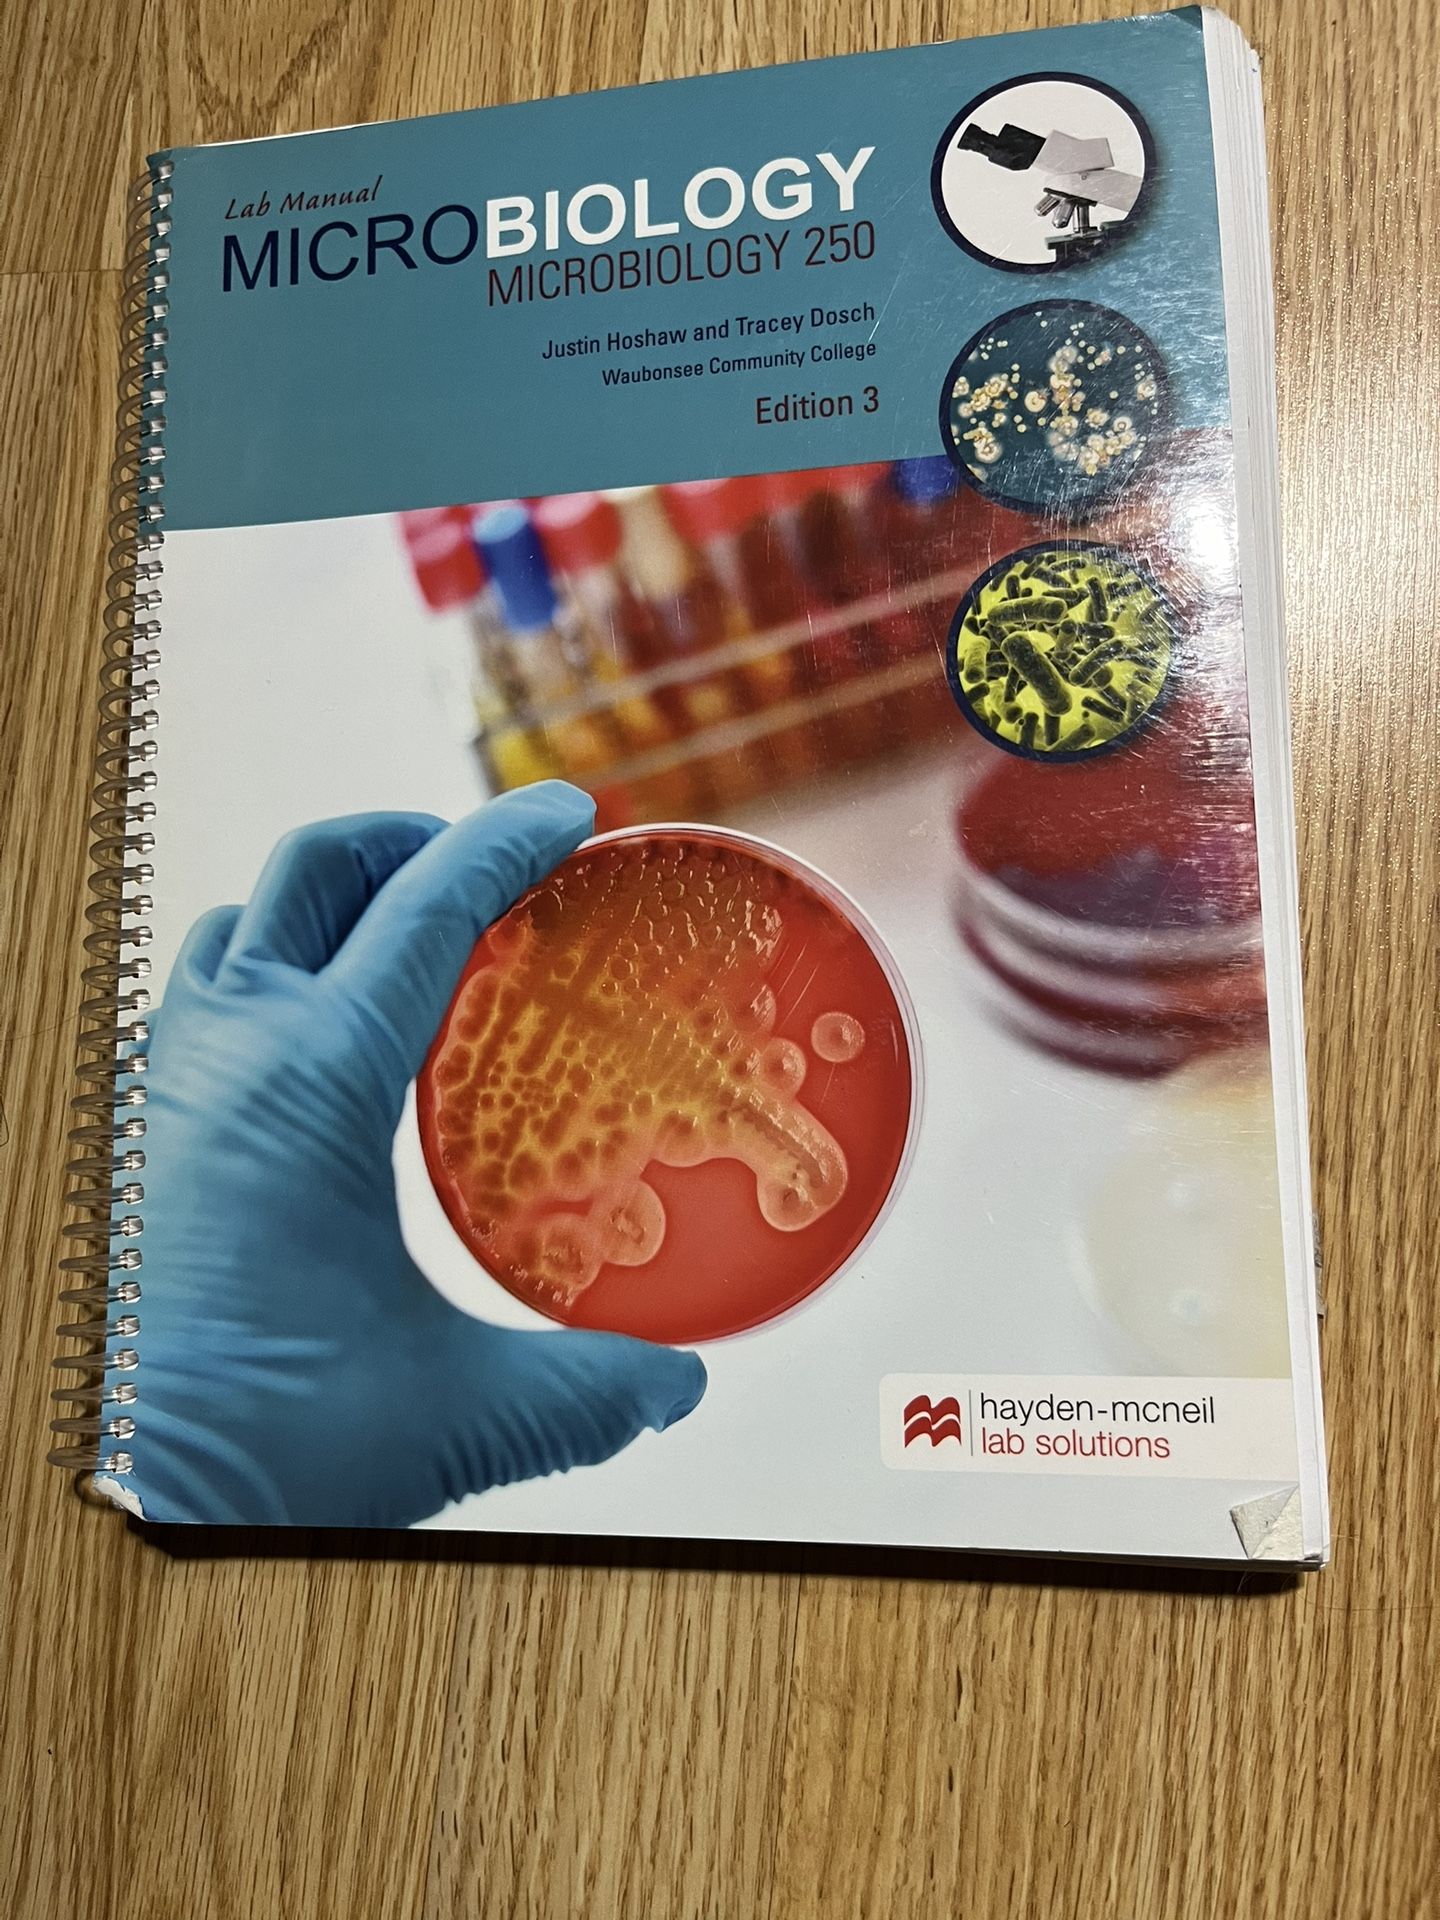

Take action
$75
Microbiology 250 Lab Manual
Ships for $4.49
Posted over 1 year ago in Aurora, IL
Listed in categories:
Sold by
Get a second opinion
Chat securely on the app
2-Day Purchase Protection
Items shipped through OfferUp come with a 2-day purchase protection.
Additional images
Description
By Justin Hoshaw and Tracey Dosch Edition 3
All content is available to screen readers from the outset. The See more button is for visual users only to expose content incrementally that is already available to you
Details
Condition
Used (normal wear)
Genre
Educational, Medical & Health
All content is available to screen readers from the outset. The See more button is for visual users only to expose content incrementally that is already available to you
Item location map
Map is approximate to keep seller’s location private.